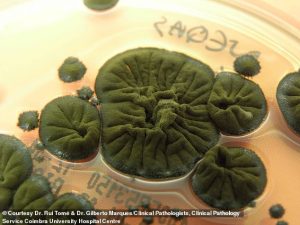
A dark green mold known as Cladosporium sphaerospermum has been found to feed on nuclear radiation, making it a potential building material for future moon bases

Key Takeaways
- A black fungus from Chernobyl feeds on radiation, turning gamma rays into energy.
- NASA is testing it as a lightweight shield for moon and Mars bases.
- Wolves and frogs in the Exclusion Zone have evolved genetic protections against cancer.
Scientists have discovered a life form thriving on the deadly radiation left by the Chernobyl nuclear disaster. A black fungus not only survives but grows faster and moves towards radiation, offering potential breakthroughs for space exploration and medicine.
The fungus, Cladosporium sphaerospermum, was found growing on the walls of the abandoned reactor. Research shows specific strains can convert dangerous gamma rays into chemical energy, a process scientists call ‘radiosynthesis’.
From Chernobyl Walls to Space Shields
The key to the fungus’s ability is melanin, the same pigment found in human skin. While melanin usually blocks UV rays, in this fungus, it transforms gamma radiation into usable energy at the atomic level.
This discovery has captured NASA’s attention. On the International Space Station, the fungus grew 21 times faster when exposed to space radiation and effectively blocked it. Scientists are now developing ‘fungal bricks’ as lightweight, superior alternatives to lead for shielding moon and Mars bases.
The material could also help clean up nuclear waste sites on Earth.
The Chernobyl Exclusion Zone: A Living Laboratory
The 1986 Chernobyl disaster created the largest uncontrolled release of radioactive material in history. The resulting 30-mile Exclusion Zone, though largely deserted by humans, has become an unexpected haven for wildlife.
This environment has forced rapid evolution. Studies reveal that wolves living in the zone have developed genetic mutations that appear to grant them resilience to cancer. Researchers from Princeton University, led by evolutionary biologist Cara Love, collected blood samples and used GPS collars with dosimeters to study these wolves in 2014.
The hope is that understanding these animal adaptations could lead to identifying protective genetic mutations in humans.
Melanin’s Protective Power
The story of adaptation extends to amphibians. Chernobyl’s tree frogs have evolved darker skin due to increased melanin. This change not only protects them but is passed to healthier offspring, creating a generational shield against radiation.
From a radiation-eating fungus to cancer-resistant wolves, life in Chernobyl is demonstrating remarkable resilience. These discoveries are turning a site of tragedy into a source of potential solutions for space travel, medicine, and environmental cleanup.